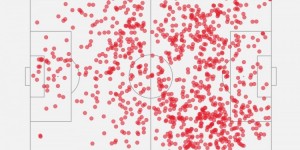
<?php the_title(); ?>

龙8国际官网报道
龙8国际-龙8国际官网-龙八国际娱乐官网-龙八国际娱乐下载(www.l8gjw.com)全球最佳老虎机平台,每日存款送3888元!
球盟会-球盟会官网-球盟会体育是亚洲老牌娱乐平台(www.qmhtyw.com)最好足球投注平台,开户送88元,美女宝贝空降!
千亿体育_千亿体育官网_千亿APP_千亿体育平台(www.qytygw.com)会员自助返水最高28888元,千亿宝贝等你撩
乐虎国际-乐虎国际官网-乐虎棋牌游戏官网-乐虎体育app下载(www.lhgjgw.com)真人百家乐连赢,最高88888,让您喜上加喜!
唯彩看球讯球迷朋友们好,欢迎收看竞彩综述,昨日虽然仅有五场竞彩足球,但高危数据并不少,难度还是不小的。意甲赛场方面,亚特兰大顶着欧洲数据1.64的高危数字成功打出,做客3-0完胜恩波利。而拉齐奥的数据也同样危险,以-0.25搭配高数据开局,全场比赛也并无获得太多机会,似乎将要被近期状态在线的佛罗伦萨闷死,直到补时第5分钟比赛读秒阶段,贝西诺成功造点,因莫比莱点射破门,蓝鹰才惊险守住主场。

其他赛事方面,莫尔德在临场保持-0.75加低数据的情况下1-4被特罗姆瑟暴打,打出一个不小的冷门,而比利亚雷亚尔同样是顶着做客-0.25搭配高数据的高危数值。靠着瑟洛特、莫雷诺的优秀发挥,最终是3-2险胜格拉纳达,葡超赛场是本轮唯一一场数据与赛果都稳健打出的赛事,欧洲数据临场已经掉到1.36,而亚洲数据也是在主队+1.25的数据站得极其稳健,最终葡萄牙体育也是做客2-0轻松击败博阿维斯塔,拿下该场赛事的胜利。
龙8国际-龙8国际官网-龙八国际娱乐官网-龙八国际娱乐下载(www.l8gjw.com)全球最佳老虎机平台,每日存款送3888元!
球盟会-球盟会官网-球盟会体育是亚洲老牌娱乐平台(www.qmhtyw.com)最好足球投注平台,开户送88元,美女宝贝空降!
千亿体育_千亿体育官网_千亿APP_千亿体育平台(www.qytygw.com)会员自助返水最高28888元,千亿宝贝等你撩
乐虎国际-乐虎国际官网-乐虎棋牌游戏官网-乐虎体育app下载(www.lhgjgw.com)真人百家乐连赢,最高88888,让您喜上加喜!
以上内容由龙8娱乐|龙8国际官网(www.l8ylgw.com)整理发布。